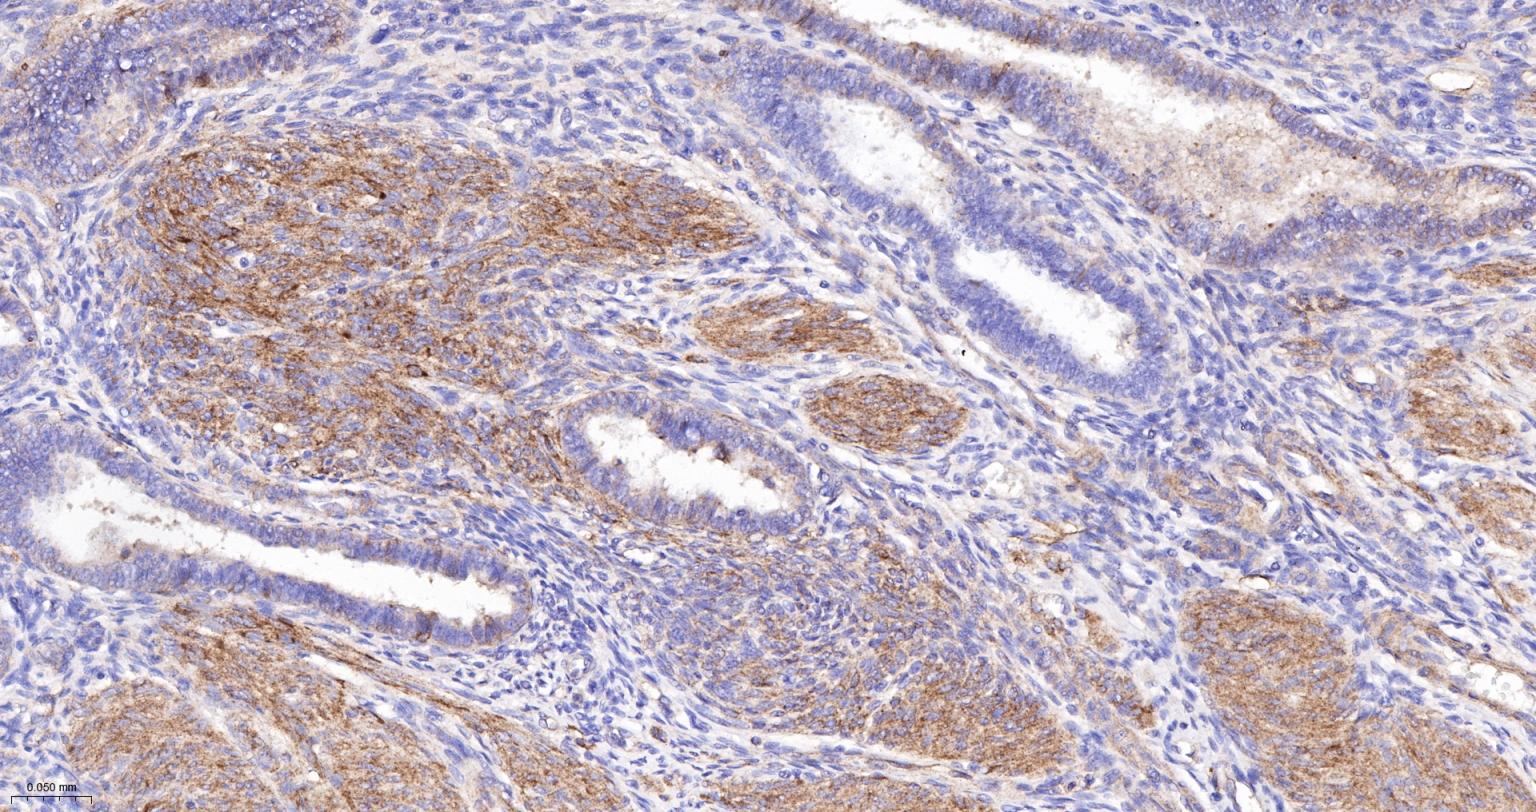
粘着斑蛋白（内参）重组兔单抗
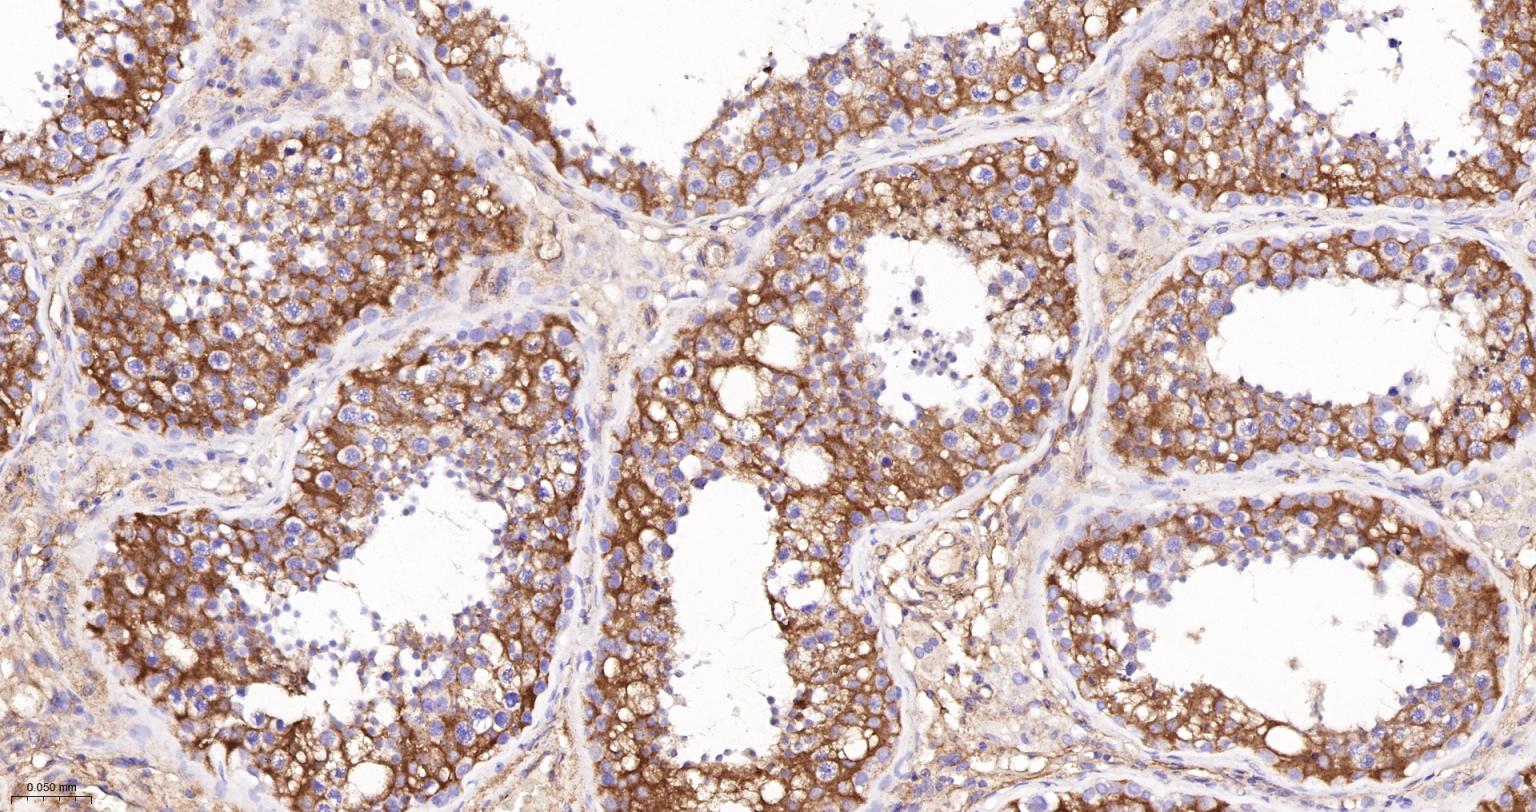
粘着斑蛋白（内参）重组兔单抗

Vinculin Recombinant Rabbit mAb, Loading Control (一抗) - WB,IHC-P,IHC-F,IF | Bioss
Rrmab?兔单抗

货号:bsm-54148R
产品详情
相关标记
相关产品
相关文献
常见问题
概述
产品编号
bsm-54148R
产品类型
内参抗体、重组兔单抗、胞质(包浆或全细胞)内参抗体、mIHC精品抗体
英文名称
Vinculin Recombinant Rabbit mAb, Loading Control
中文名称
粘着斑蛋白(内参)重组兔单抗
英文别名
CMD1W; CMH15; HEL114; MV; MVCL; VINC; 9430097D22; VINC_HUMAN; VCL; Metavinculin (MV); VINC_MOUSE; Metavinculin; VINC_RAT; vinculin
抗体来源
Rabbit
免疫原
Recombinant Human Vinculin
亚型
IgG
性状
Liquid
纯化方法
affinity purified by Protein A
克隆类型
Recombinant
克隆号
5G7
理论分子量
124 kDa
检测分子量
125 kDa
浓度
1mg/ml
储存液
0.01M TBS (pH7.4) with 1% BSA, 0.02% Proclin300 and 50% Glycerol.
研究领域
SWISS
Gene ID
保存条件
Shipped at 4℃. Store at -20℃ for one year. Avoid repeated freeze/thaw cycles.
注意事项
This product as supplied is intended for research use only, not for use in human, therapeutic or diagnostic applications.
数据库链接
背景资料
Vinculin is a cytoskeletal protein associated with cell-cell and cell-matrix junctions, where it is thought to function as one of several interacting proteins involved in anchoring F-actin to the membrane. Defects in VCL are the cause of cardiomyopathy dilated type 1W. Dilated cardiomyopathy is a disorder characterized by ventricular dilation and impaired systolic function, resulting in congestive heart failure and arrhythmia. Multiple alternatively spliced transcript variants have been found for this gene, but the biological validity of some variants has not been determined. [provided by RefSeq, Jul 2008]

产品应用
| 应用 | 已检合格种属 | 预测种属 | 推荐稀释比例 |
|---|---|---|---|
| WB | Human, Mouse, Rat | 1:1000-2000 | |
| IHC-P | Human, Mouse, Rat | 1:500-2000 | |
| IHC-F | Human, Mouse, Rat | 1:500-2000 | |
| IF | Human, Mouse, Rat | 1:500-2000 |
交叉反应
交叉反应: Human, Mouse, Rat
相关产品
暂无相关产品
靶标
基因名
VCL
蛋白名
Vinculin
亚基
Exhibits self-association properties. Interacts with NRAP and SORBS1 (By similarity). Interacts with TLN1. Interacts with SYNM. Interacts with CTNNB1 and this interaction is necessary for its localization to the cell-cell junctions and for its function in regulating cell surface expression of E-cadherin.
亚细胞定位
Cytoplasm, cytoskeleton. Cell junction, adherens junction. Cell membrane; Peripheral membrane protein; Cytoplasmic side.
组织特异性
Metavinculin is muscle-specific.
翻译后修饰
Phosphorylated; on serines, threonines and tyrosines. Phosphorylation on Tyr-1133 in activated platelets affects head-tail interactions and cell spreading but has no effect on actin binding nor on localization to focal adhesion plaques (By similarity).
Aceylated; mainly by myristic acid but also small amount of palmitic acid (By similarity).
Aceylated; mainly by myristic acid but also small amount of palmitic acid (By similarity).
疾病
Defects in VCL are the cause of cardiomyopathy dilated type 1W (CMD1W) [MIM:611407]. Dilated cardiomyopathy is a disorder characterized by ventricular dilation and impaired systolic function, resulting in congestive heart failure and arrhythmia. Patients are at risk of premature death.
Defects in VCL are the cause of cardiomyopathy familial hypertrophic type 15 (CMH15) [MIM:613255]. It is a hereditary heart disorder characterized by ventricular hypertrophy, which is usually asymmetric and often involves the interventricular septum. The symptoms include dyspnea, syncope, collapse, palpitations, and chest pain. They can be readily provoked by exercise. The disorder has inter- and intrafamilial variability ranging from benign to malignant forms with high risk of cardiac failure and sudden cardiac death.
Defects in VCL are the cause of cardiomyopathy familial hypertrophic type 15 (CMH15) [MIM:613255]. It is a hereditary heart disorder characterized by ventricular hypertrophy, which is usually asymmetric and often involves the interventricular septum. The symptoms include dyspnea, syncope, collapse, palpitations, and chest pain. They can be readily provoked by exercise. The disorder has inter- and intrafamilial variability ranging from benign to malignant forms with high risk of cardiac failure and sudden cardiac death.
相似性
Belongs to the vinculin/alpha-catenin family.
功能
Actin filament (F-actin)-binding protein involved in cell-matrix adhesion and cell-cell adhesion. Regulates cell-surface E-cadherin expression and potentiates mechanosensing by the E-cadherin complex. May also play important roles in cell morphology and locomotion.
同靶标产品
相关文献
提示: 发表研究结果有使用 bsm-54148R 时请让我们知道,以便我们可以引用参考文章。作为回馈,资料提供者将获得我们送上的小礼品。
具体参考文献:bsm-54148R 被引用于5文献中